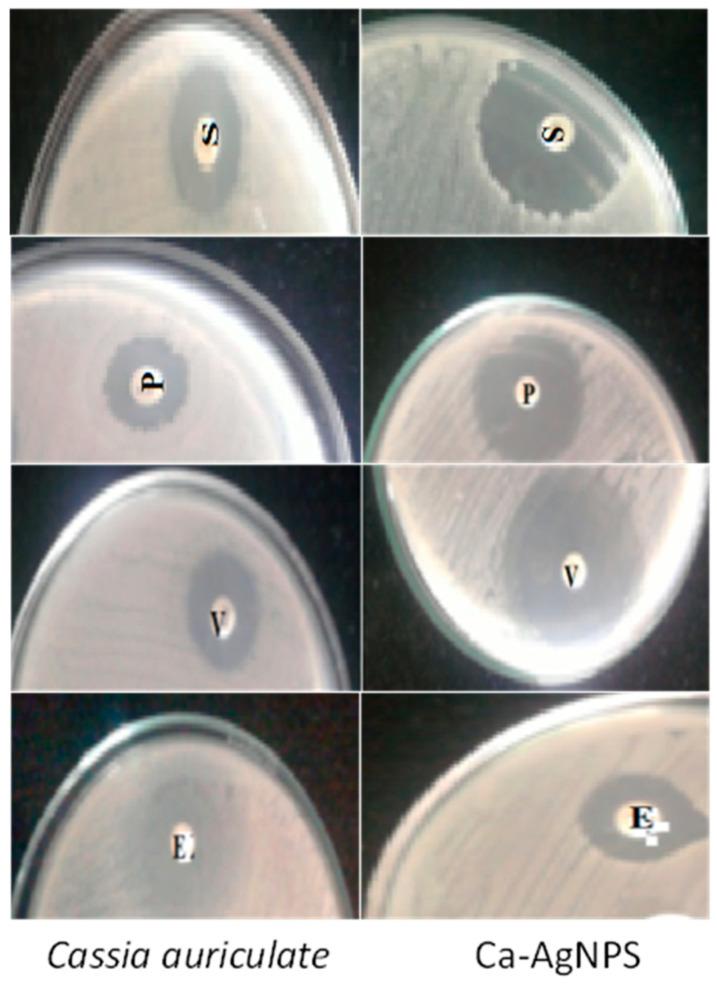
https://cdn.ncbi.nlm.nih.gov/pmc/blobs/5184/9961718/43896924dc78/plants-12-00707-g004.jpg

利用花提取物生物合成银纳米颗粒的表征及治疗应用
Characterization and Therapeutic Applications of Biosynthesized Silver Nanoparticles Using Flower Extract.
作者信息
Sabapathi Nadana, Ramalingam Srinivasan, Aruljothi Kandasamy Nagarajan, Lee Jintae, Barathi Selvaraj
机构信息
Guangdong Key Laboratory for Genome Stability and Disease Prevention, School of Medicine, Shenzhen University, Shenzhen 518060, China.
Department of Horticulture & Life Science, Yeungnam University, Gyeongsan-si 38541, Republic of Korea.
出版信息
Plants (Basel). 2023 Feb 5;12(4):707. doi: 10.3390/plants12040707.
The current study analyzes the biosynthesis of silver nanoparticles using the flower extract as the reducing and stabilizing agent. The - silver nanoparticles (Ca-AgNPs) obtained are characterized by UV-Vis spectroscopy, Fourier transform infrared (FT-IR) spectroscopy, X-ray diffraction (XRD), scanning electron microscopy (SEM), and transmission electron microscopy (TEM) analysis. The results of the spectral characterization have revealed that the surface Plasmon resonance band observed at 448 nm confirms the formation of AgNPs. TEM analysis of the Ca-AgNPs was a predominately spherical shape with a size assortment of 30 to 80 nm and an angular size of 50 nm. The well-analyzed Ca-AgNPs were used in various biological assays, including healthcare analysis of antimicrobial, antioxidant (DPPH), and cytotoxic investigations. Ca-AgNPs showed efficient free radical scavenging activity and showed excellent antimicrobial activity against to pathogenic strains. The occurrence of Ca-AgNPs lead to reduced Live/Dead ratio of bacteria (from 36.97 ± 1.35 to 9.43 ± 0.27) but improved the accumulation of bacterial clusters. The cytotoxicity of Ca-AgNPs was carried out by MTT assay against MCF-7 breast cancer cells and a moderate cytotoxic. The approach of flower extract-mediated synthesis is a cost-efficient, eco-friendly, and easy alternative to conventional methods of silver nanoparticle synthesis.
本研究分析了以花提取物作为还原剂和稳定剂来生物合成银纳米颗粒。所获得的钙银纳米颗粒(Ca-AgNPs)通过紫外-可见光谱、傅里叶变换红外(FT-IR)光谱、X射线衍射(XRD)、扫描电子显微镜(SEM)和透射电子显微镜(TEM)分析进行表征。光谱表征结果表明,在448nm处观察到的表面等离子体共振带证实了AgNPs的形成。对Ca-AgNPs的TEM分析显示其主要为球形,尺寸范围为30至80nm,角尺寸为50nm。经过充分分析的Ca-AgNPs被用于各种生物学检测,包括抗菌、抗氧化(DPPH)的医疗保健分析以及细胞毒性研究。Ca-AgNPs表现出高效的自由基清除活性,并对致病菌株表现出优异的抗菌活性。Ca-AgNPs的出现导致细菌的活/死比率降低(从36.97±1.35降至9.43±0.27),但改善了细菌聚集体的积累。通过MTT法对MCF-7乳腺癌细胞进行了Ca-AgNPs的细胞毒性测试,结果显示具有中等细胞毒性。花提取物介导的合成方法是一种经济高效、环境友好且比传统银纳米颗粒合成方法更简便的替代方法。